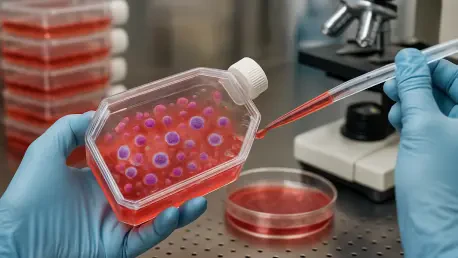
Why Is Big Pharma Divided on Cell Therapy?

Johnson & Johnson’s monumental decision to construct a new $1 billion cell and gene therapy manufacturing site in the United States has cast a brilliant light on a profound strategic rift developing within the pharmaceutical industry. This significant investment is not merely a component of a larger trend toward onshoring drug production; it serves as a clear declaration in a high-stakes debate over the future of one of medicine’s most complex and promising modalities. While some industry titans are pouring billions into cell and gene therapy, others are conspicuously stepping back, creating a polarized landscape that will undoubtedly shape the course of advanced medical treatments for years to come. This divergence reveals fundamental disagreements about risk, cost, and the ultimate commercial viability of therapies that are as revolutionary as they are challenging to produce.
Johnson & Johnson’s Billion-Dollar Bet on Domestic Cell Therapy
A State-of-the-Art Facility Driven by Blockbuster Success
At the core of Johnson & Johnson’s strategy is the development of a state-of-the-art, next-generation cell therapy production plant located in Montgomery County, Pennsylvania. This ambitious $1 billion project represents a substantial commitment to both the regional economy and the advanced therapy sector, projecting an infusion of over 500 permanent, highly skilled biomanufacturing positions once operational, along with an additional 4,000 jobs during its construction phase. This new site will mark the company’s eleventh facility within Pennsylvania, a state where it already maintains a considerable operational footprint that includes manufacturing, distribution, research, and corporate offices. The decision to build a next-generation facility underscores the unique and intricate challenges of cell therapy manufacturing, which requires specialized environments and highly controlled processes to handle living cellular material, a stark departure from traditional small molecule or biologic drug production. This investment signals a belief that mastering these complex logistics is key to future market leadership.
The strategic rationale for this massive expenditure is directly underpinned by the extraordinary commercial success of Johnson & Johnson’s existing cell therapy product, Carvykti (ciltacabtagene autoleucel). Having already achieved blockbuster status in the fiscal year 2025 with an impressive $1.9 billion in global sales, market projections forecast a dramatic surge in annual revenue, expected to reach $7.8 billion by 2031. This explosive growth trajectory creates a pressing and undeniable need for a significant expansion of manufacturing capacity to meet anticipated future demand. The Pennsylvania facility is therefore a direct response to this commercial imperative, designed to alleviate potential supply chain bottlenecks that could otherwise hinder the product’s market penetration. For autologous therapies like Carvykti, which are created on a per-patient basis, scaling production is a logistical hurdle that requires dedicated, high-capacity infrastructure to ensure timely and reliable treatment delivery to a growing patient population worldwide.
Part of a Broader U.S. Manufacturing and Onshoring Push
The new Pennsylvania plant is a critical component of a much larger and more comprehensive strategic initiative by Johnson & Johnson. It stands as one of four new U.S.-based manufacturing sites the company intends to construct over the next four years, all falling under an immense $55 billion plan designed to substantially bolster its domestic production presence. This is not an isolated investment but part of a calculated corporate pivot. Another significant project within this initiative is the ongoing construction of a $2 billion biologics production facility in Wilson, North Carolina, demonstrating a broad-based commitment to bringing advanced manufacturing capabilities back to the United States. This strategic realignment is also influenced by geopolitical and economic factors, such as the company’s negotiation of a Most Favored Nation (MFN) deal with the White House, a proactive move aimed at mitigating the financial risks associated with potential 100% tariffs on its imported branded pharmaceutical products.
Johnson & Johnson’s strategic shift toward domestic manufacturing is in perfect alignment with a broader trend currently sweeping across the pharmaceutical industry. This movement to onshore drug production and fortify national supply chains has been heavily influenced by the policy goals of the Trump administration, which has consistently emphasized the importance of reducing the nation’s reliance on foreign manufacturing for critical medicines. As this onshoring trend gains momentum, industry experts predict a corresponding rise in the prominence of newer biotechnology hubs, particularly in states like North Carolina and Virginia. These regions are poised to attract significant further investment, which will help diversify the national biomanufacturing landscape beyond traditional centers of activity. This broader movement reflects a growing recognition that supply chain resilience is a matter of both economic stability and national security, a lesson reinforced by recent global disruptions.
A Fork in the Road: The Great Pharma Divide on CGT
The Retreat: Why Some Giants Are Stepping Away
While Johnson & Johnson is clearly doubling down on its investment in cell and gene therapy, this fervent enthusiasm is not a universally shared sentiment across the pharmaceutical and biotech sectors. The industry currently appears to be at a strategic crossroads, with major players making starkly different and often contradictory choices regarding the future of this advanced modality. This divergence is not subtle; it represents a fundamental split in corporate philosophy on how to approach high-risk, high-reward therapeutic areas. On one side of this divide, several prominent companies have recently made definitive moves to retreat from the CGT space, citing the immense costs, complex manufacturing logistics, and uncertain reimbursement landscapes as key deterrents. These decisions reflect a strategic prioritization of more established and predictable therapeutic platforms over the pioneering but volatile field of cell therapy.
This strategic withdrawal was highlighted in late 2025 when Takeda publicly announced its decision to step away from cell therapy entirely, choosing instead to concentrate its valuable resources on the development of small molecules, biologics, and antibody-drug conjugates (ADCs). This move sent a significant signal to the market about the perceived risks of the CGT sector. During the same period, both Novo Nordisk and Galapagos made similar strategic pivots, each making the decision to shutter their respective units that had been focused on cell therapies. These concurrent exits by major industry players underscore a growing sentiment that, despite its revolutionary potential, the operational and financial burdens of developing and commercializing cell therapies may outweigh the potential returns for some companies. This calculated retreat allows them to reallocate capital to areas with a clearer and potentially faster path to market and profitability.
The Advance: Others Double Down Amid a Shifting Investment Landscape
In stark contrast to the strategic retreats, other pharmaceutical giants are aggressively expanding their presence in the cell and gene therapy field, mirroring Johnson & Johnson’s bullish and forward-looking stance. Eli Lilly, for instance, has demonstrated a powerful commitment to the modality through two blockbuster deals in 2026 alone. The company finalized a $1.1 billion agreement with Seamless Therapeutics, which is focused on the cutting edge of gene therapy, and followed up with a deal worth up to $2.4 billion with Orna Therapeutics for the development of innovative in vivo CAR-T therapies. Similarly, Bristol Myers Squibb (BMS), a company that already markets two approved and successful CAR-T therapies, has chosen to deepen its investment by acquiring Orbital Therapeutics in a significant $1.5 billion buyout, further cementing its leadership position in the field and signaling long-term confidence in the modality’s growth.
This profound divergence in corporate strategy is also clearly reflected in the CGT investment landscape, particularly within the realm of venture capital funding. According to a recent industry report, venture capital activity in the sector is undergoing a significant and telling shift. Investors are becoming increasingly selective and risk-averse, now preferring to allocate their capital to companies that have successfully navigated beyond the early, high-risk preclinical stages of development. This trend is evidenced by the finding that a full 50% of all venture capital activity in the cell and gene therapy space is now concentrated at the Series B financing stage. This stage typically marks a company’s transition from preclinical research to clinical execution, indicating that investors are placing a premium on assets that are supported by stronger clinical data and possess a clearer, more de-risked path to market approval in this complex and capital-intensive field.
Charting a Path Through a Divided Industry
The strategic decisions made across the pharmaceutical sector revealed a landscape of profound uncertainty and calculated risk. While some major players stepped back from cell and gene therapy, daunted by the immense financial and logistical hurdles, others charged forward with billion-dollar investments, confident in the modality’s revolutionary potential. This divergence was not a sign of industry-wide failure but rather a natural maturation of a disruptive field, where companies were forced to align their strategies with their unique risk tolerances and core competencies. The selective nature of venture capital, which gravitated toward later-stage assets with validated clinical data, further underscored a market that was learning to distinguish between speculative promise and tangible progress. Ultimately, this period of strategic realignment paved the way for a more focused and sustainable path forward for cell and gene therapies, driven by those with the capital, expertise, and conviction to overcome its formidable challenges.